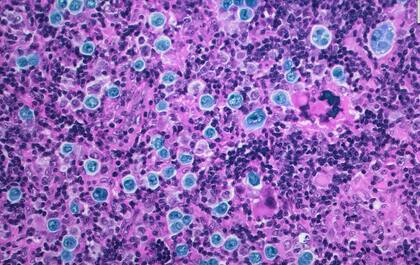
Una micrografía de luz a color de una sección de una biopsia de ganglio linfático de un paciente con linfoma difuso de células B grandes, que muestra células grandes anormales diseminadas de manera difusa

El biólogo que caminaba por un bosque de secuoyas y tuvo una epifanía: crear una molécula para que el cáncer se autodestruya
Investigadores de la Universidad Stanford idearon una nueva y extraña molécula que podría conducir a medicamentos que armen genes y hagan que los cánceres actúen contra ellos mismos
 5 minutos de lectura'
5 minutos de lectura'

En todo tipo de cáncer hay moléculas que aceleran un crecimiento incontrolable y mortal. ¿Qué pasaría si los científicos pudieran enganchar esas moléculas con otras que hicieran que las células se autodestruyeran? ¿Qué pasaría si aquello que impulsa la supervivencia de un cáncer pudiera en su lugar activar el programa para su destrucción?
Hace algunos años, durante una caminata por un bosque de secuoyas cercano a su casa en las montañas de Santa Cruz, esa idea fue una epifanía para Gerald Crabtree, biólogo del desarrollo de la Universidad Stanford.
“Regresé corriendo a casa”, recordó, emocionado por la idea y pensando en la manera de llevarla a cabo.
Ahora, en un artículo que se publicó el 26 de julio en la revista Nature, Crabtree, uno de los fundadores de Shenandoah Therapeutics, que desarrolla medicamentos contra el cáncer, junto con Nathanael Gray, profesor de biología química y sistemas en Stanford, y sus colegas informan que lograron lo que él imaginó en aquel paseo. Aunque el concepto está muy lejos de ser un fármaco que pueda administrarse a pacientes con cáncer, podría ser un objetivo para los desarrolladores de medicamentos en el futuro.
“Es fantástico”, comentó Jason Gestwicki, profesor de química farmacéutica de la Universidad de California, en San Francisco. “Convierte algo que el cáncer necesita para mantenerse vivo en algo que lo mata, como cambiar tus vitaminas por veneno”.
Louis Staudt, director del Centro de Genómica del Cáncer del Instituto Nacional del Cáncer, afirmó: “Esta podría ser una nueva manera de que el cáncer actúe en su contra”. Staudt escribió un editorial para acompañar el artículo de Crabtree.
Una vez que el tratamiento se desarrolle más, añadió, “me encantaría probarlo en un ensayo clínico con nuestros pacientes que hayan agotado todas las demás opciones”.
En experimentos de laboratorio con células de un cáncer en la sangre, el linfoma difuso de células B grandes, los investigadores diseñaron y construyeron moléculas que enganchaban dos proteínas: la BCL6, una proteína mutada de la que depende el cáncer para crecer y sobrevivir agresivamente, y una proteína normal de la célula que activa cualquier gen al que se acerca.
La nueva construcción, una molécula con forma de mancuerna, no se parece a nada que se haya visto en la naturaleza. La proteína BCL6, en un extremo de la mancuerna, guía a la molécula hacia los genes de muerte celular que forman parte del ADN de cada célula y se utilizan para deshacerse de las células que ya no son necesarias. Pero cuando una persona tiene un linfoma difuso de células B grandes, la proteína BCL6 desactiva esos genes de muerte celular, haciendo que las células se vuelvan casi inmortales.
Cuando la mancuerna, guiada por la proteína BCL6, se acerca a los genes que provocan la muerte celular, la proteína normal al extremo de la mancuerna arma a esos genes que provocan la muerte. A diferencia de otros procesos en la célula que pueden revertirse, la activación de los genes de la muerte celular es irreversible.
La nueva estrategia podría mejorar la difícil tarea de usar medicamentos para bloquear a todas las moléculas que incluyan una proteína BCL6. Para matar a las células con las moléculas en forma de mancuerna, basta con cambiar el cableado solo de una parte de las moléculas con la proteína BCL6.
Según Crabtree, el concepto podría funcionar para la mitad de todos los tipos de cáncer, los cuales presentan mutaciones conocidas que dan lugar a proteínas que impulsan el crecimiento. Y como el tratamiento se basa en las proteínas mutadas producidas por las células cancerosas, podría ser sumamente específico y no afectar a las células sanas.
Áreas de descubrimiento
Crabtree explicó cuáles son las dos áreas de descubrimiento que hicieron posible este trabajo. Una es el descubrimiento de “genes impulsores”, varios cientos de genes que, al mutar, impulsan la propagación del cáncer.
La segunda es el descubrimiento de vías que conducen a la muerte en las células. Según Crabtree, esas vías se utilizan para eliminar células que, por alguna razón, se rebelan; son alrededor de 60.000 millones de células diarias en cada individuo.
El objetivo era lograr que las vías que impulsan el crecimiento de las células cancerosas se comunicaran con las vías silenciadas que impulsan la muerte celular, algo que normalmente no harían.
Cuando la molécula híbrida llegó al ADN de las células, no solo activó los genes de la muerte celular, sino que hizo algo más. La molécula con la proteína BCL6 llevó a la molécula híbrida hasta otros genes que el cáncer había silenciado. La molécula híbrida volvió a activar esos genes, creando un caos interno en la célula.
“La célula nunca había experimentado algo así”, afirmó Staudt.
“La molécula con la proteína BCL6 es el principio organizador de esas células cancerosas”, explicó. Cuando su función se ve afectada por completo, “la célula pierde su identidad y dice: ‘Aquí está pasando algo muy malo. Mejor me muero’”.
Pero el principal efecto del tratamiento experimental fue activar los genes de muerte celular, comentó Crabtree. “Ese es el efecto terapéutico”, afirmó.
El grupo probó su molécula híbrida en ratones, donde parecía segura. Pero, como bien señaló Staudt: “los humanos son muy diferentes a los ratones”.
Stuart Schreiber, catedrático de química y biología química de la Universidad de Harvard y antiguo colaborador de Crabtree concuerda en que el trabajo es “apasionante”. Pero hizo una advertencia.
Lo que Crabtree ha creado “no es un fármaco; aún le queda mucho camino por recorrer”, afirmó.
Por Gina Kolata
- 1
Subasta sin compradores: el Gobierno no logró vender el terreno de la polémica en Almagro
 2
2Comenzaron las obras: así será el nuevo espacio verde que beneficiará a 70.000 vecinos y promete transformar la zona norte de la Ciudad
 3
3Cómo viajo en CABA: así se usa el mapa interactivo para saber cómo llegar a una dirección en subte, colectivo o caminando
 4
4Revelador hallazgo: un fósil patagónico cambia la perspectiva sobre un enigmático grupo de pequeños dinosaurios carnívoros





